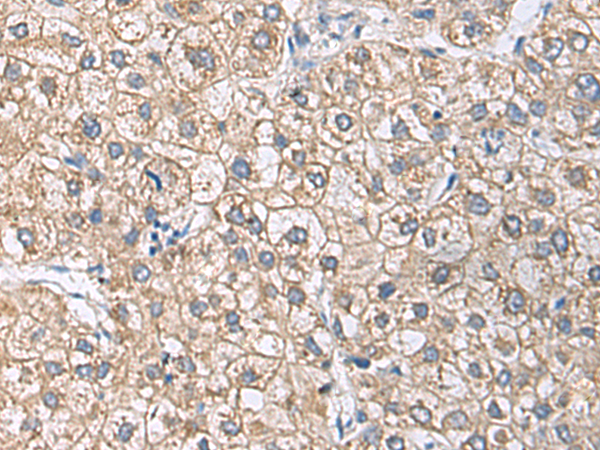

中文名稱: 兔抗UBE2N多克隆抗體
|
Background: |
The modification of proteins with ubiquitin is an important cellular mechanism for targeting abnormal or short-lived proteins for degradation. Ubiquitination involves at least three classes of enzymes: ubiquitin-activating enzymes, or E1s, ubiquitin-conjugating enzymes, or E2s, and ubiquitin-protein ligases, or E3s. This gene encodes a member of the E2 ubiquitin-conjugating enzyme family. Studies in mouse suggest that this protein plays a role in DNA postreplication repair. |
|
Applications: |
ELISA, WB, IHC |
|
Name of antibody: |
UBE2N |
|
Immunogen: |
Synthetic peptide of human UBE2N |
|
Full name: |
ubiquitin conjugating enzyme E2 N |
|
Synonyms: |
UBC13; UbcH13; HEL-S-71; UbcH-ben; UBCHBEN; UBC13 |
|
SwissProt: |
P61088 |
|
ELISA Recommended dilution: |
5000-10000 |
|
IHC positive control: |
Human liver cancer and Human ovarian cancer |
|
IHC Recommend dilution: |
50-200 |
|
WB Predicted band size: |
17 kDa |
|
WB Positive control: |
Mouse brain tissue, Hela cell, LNCAP cell, HepG2 cell, Jurkat cell lysates |
|
WB Recommended dilution: |
500-2000 |

購物車
購物車 幫助
幫助
 021-54845833/15800441009
021-54845833/15800441009
